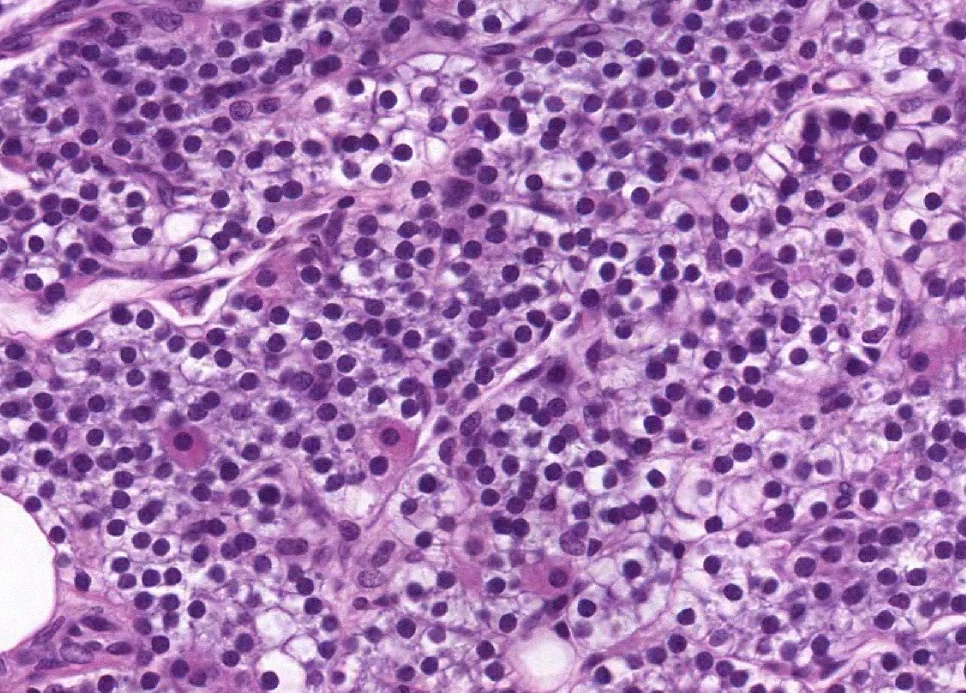

暂无搜索结果
-
1 第一单元 绪论
-
1.1 组织切片制作微课
-
1.2 绪论课件
-
1.3 绪论作业
-
2 第二单元 上皮组织
-
2.1 上皮组织切片库
-
2.2 上皮组织微课
-
2.3 上皮组织课件
-
2.4 上皮组织作业
-
2.5 学生绘图
-
3 第三单元 结缔组织
-
3.1 固有结缔组织
-
3.1.1 固有结缔组织切片库
-
3.1.2 固有结缔组织微课
-
3.1.3 固有结缔组织课件
-
3.1.4 固有结缔组织作业
-
3.1.5 学生绘图
-
3.2 软骨和骨
-
3.2.1 软骨与骨切片库
-
3.2.2 软骨与骨微课
-
3.2.3 软骨课件
-
3.2.4 软骨与骨作业
-
3.2.5 学生绘图
-
3.3 血液
-
3.3.1 血液切片库
-
3.3.2 血液微课
-
3.3.3 血液课件
-
3.3.4 血液作业
-
3.3.5 学生绘图
-
4 第四单元 肌组织
-
4.1 肌组织切片库
-
4.2 肌组织微课
-
4.3 肌组织课件
-
4.4 肌组织作业
-
4.5 学生绘图
-
5 第五单元 神经组织
-
5.1 神经组织切片库
-
5.2 神经组织微课
-
5.3 神经组织课件
-
5.4 神经组织作业
-
5.5 学生绘图
-
6 第六单元 循环系统
-
6.1 循环系统切片库
-
6.2 循环系统微课
-
6.3 循环系统课件
-
6.4 循环系统作业
-
6.5 学生绘图
-
7 第七单元 免疫系统
-
7.1 免疫系统切片库
-
7.2 免疫系统微课
-
7.3 免疫系统课件
-
7.4 免疫系统作业
-
7.5 学生绘图
-
8 第八单元 内分泌系统
-
8.1 内分泌系统切片库
-
8.2 内分泌系统微课
-
8.3 内分泌系统课件
-
8.4 内分泌系统作业
-
8.5 学生绘图
-
9 第九单元 皮肤
-
9.1 皮肤切片库
-
9.2 皮肤微课
-
9.3 皮肤课件
-
9.4 皮肤作业
-
9.5 学生绘图
-
10 第十单元 消化系统
-
10.1 消化管切片库
-
10.2 消化管微课
-
10.3 消化管课件
-
10.4 消化管作业
-
10.5 消化管学生绘图
-
10.6 消化腺切片库
-
10.7 消化腺微课
-
10.8 消化腺课件
-
10.9 消化腺作业
-
10.10 消化腺学生绘图
-
11 第十一单元 呼吸系统
-
11.1 呼吸系统切片库
-
11.2 呼吸系统微课
-
11.3 呼吸系统课件
-
11.4 呼吸系统作业
-
11.5 学生绘图
-
12 第十二单元 泌尿系统
-
12.1 泌尿系统切片库
-
12.2 泌尿系统微课
-
12.3 泌尿系统课件
-
12.4 泌尿系统作业
-
12.5 学生绘图
-
13 第十三单元 生殖系统
-
13.1 男性生殖系统切片库
-
13.2 男性生殖系统微课
-
13.3 男性生殖系统课件
-
13.4 男性生殖系统作业
-
13.5 学生绘图
-
13.6 女性生殖系统切片库
-
13.7 女性生殖系统微课
-
13.8 女性生殖系统课件
-
13.9 女性生殖系统作业
-
13.10 学生绘图
-
14 第十四单元 人体胚胎学概要
-
14.1 胚胎的早期发育微课
-
14.2 胚胎早期发育课件
-
14.3 胚胎的早期发育作业
-
14.4 学生绘图

选择班级